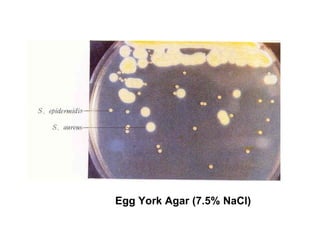
Egg York Agar (7.5% NaCl)

Gli stafilococchi sono batteri Gram positivi e catalasi positivi, caratterizzati dalla loro capacità di colonizzare la pelle e le mucose umane. Tra le specie, Staphylococcus aureus è il principale patogeno, responsabile di infezioni gravi e sindromi tossiche, mentre Staphylococcus epidermidis è un commensale che può causare infezioni opportunistiche. La virulenza è facilitata da fattori come la produzione di tossine ed enzimi che danneggiano i tessuti e interferiscono con la risposta immunitaria.

![Staphylococcus aureus
Tipico colore giallo-oro delle colonie dovuto alla
presenza di carotenoidi (antiossidante). La
pigmentazione compare dopo 18-24 ore a 37°C.
Non si ha produzione di pigmento durante lo sviluppo
in condizioni anaerobiche o nei terreni liquidi.
Salt Tolerant (up to 15% [NaCl])
(Mannitol Salt Agar—7.5% NaCl)
β-hemolytic on blood agar
In agar-sangue si nota spesso un alone chiaro di emolisi intorno alle colonie.
Può produrre 4 differenti emolisine, con variabilità fra i ceppi e con differenti
specie-specificità per gli eritrociti
l’entità dell’emolisi dipende sia dal ceppo che dal tipo di sangue.](https://image.slidesharecdn.com/8-staphy-120423103533-phpapp01/85/8-staphy-10-320.jpg)







































